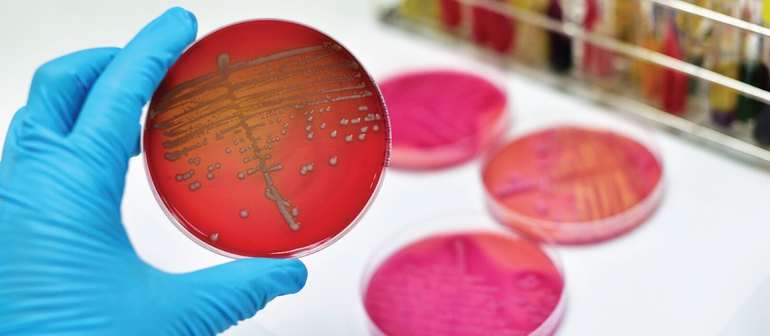
Какие мухи и почему кусаются в конце лета и осенью

Многие замечают, что с наступлением холодов некоторые насекомые становятся агрессивнее, чем обычно. Есть определённые причины того, почему мухи кусаются осенью, однако интерес к человеку и животным проявляют не все виды. Нужно знать, какие меры профилактики можно принять, когда стоит опасаться нападения и что делать, если пришлось пострадать от кровососущей особи.

Особенности осенней жигалки
Разновидностей мух очень много, но далеко не все сильно кусаются. Есть виды, которые распространены только в Сибири, например, гнус. Встречаются и экзотические двукрылые, в том числе муха-цеце, укус которой может привести к летальному исходу. Но для жителей России наибольшую опасность представляет крылатое насекомое, известное как жигалка.

Насекомое принадлежит к семейству настоящих мух. Длина тела составляет от 5 до 7 мм. Внешне взрослая особь ничем не примечательна, её легко спутать с обычной мухой, обитающей в жилых помещениях круглый год. Окраска туловища — однотонная, насыщенно-серая, грудь немного темнее, чем брюшко. На последнем есть несколько черноватых точек.
Осенние жигалки относятся к хищникам и питаются свежей кровью. Они кусают человека, млекопитающих, птиц и всех животных, чей кожный покров могут проткнуть своим хоботком. Ротовой аппарат устроен таким образом, что им муха легко прокалывает даже толстую кожу, после чего высасывает порцию крови. По краям заострённого хоботка есть зубчики. Вонзая ротовой аппарат в кожу, муха как бы бурит отверстие. Добравшись до крови, насекомое впрыскивает специальное вещество, благодаря которому кровь не свёртывается.
Опасность укуса и меры лечения
В момент укуса насекомого и сразу после него человек ощущает сильную боль. Она примерно такая, как если бы кожу обожгли крапивой, поэтому про мух часто говорят, что они «жалят». Болезненные ощущения могут продолжаться от нескольких секунд до нескольких часов. Когда муха прокалывает кожу, она впрыскивает токсичное вещество, поэтому поражённое место воспаляется.
Выраженность проблем зависит от индивидуальной восприимчивости человека. У некоторых кожа в месте укуса сильно опухает, повышается температура. Есть и такие люди, которым укус осенней мухи не причиняет сильных страданий, однако боль ощущают все. Опасность заключается не только в сиюминутном дискомфорте и страданиях. Мухи, в том числе жигалки, разносят тяжёлые заболевания. Перечень патологий, которыми может заразиться человек, укушенный двукрылой хищницей:
- трипаносомоз;
- сепсис;
- туберкулёз;
- брюшной тиф;
- дизентерия;
- сибирская язва;
- полиомиелит.
Это далеко не полный перечень всего, чем могут заболеть дети и взрослые, пострадавшие от хоботков жигалок. После укуса домашней мухи нужно незамедлительно принять меры, чтобы свести к минимуму риск заражения. Вот что следует сделать:
- хорошо промыть рану сначала мыльной, затем чистой водой;
- обработать место укуса перекисью водорода;
- смазать ранку йодом;
- принять «Супрастин» или другой препарат от аллергии;
- приложить сухой лёд или обычный, завёрнутый в полотенце (другой вариант — сделать холодный компресс);
- следить за самочувствием в течение нескольких часов;
- если состояние ухудшилось или появились странные симптомы, обратиться к врачу.
Если не произошло заражения опасным заболеванием, место укуса перестанет болеть и чесаться уже на следующий день. Незаживающая рана, припухлость или волдырь — повод обратиться за помощью. Если промедлить, может развиться заражение крови, а это чревато гангреной и последующей ампутацией.
Причина агрессивного поведения
Обычно мухи начинают кусаться в середине или конце августа, когда днём становится меньше солнца, а по ночам ощущается холод. Период, когда насекомые нападают на людей и животных, продолжается до начала ноября, но иногда заканчивается раньше, в зависимости от того, в какое время начинаются регулярные заморозки.

Кровь требуется мухам как источник питания. Однако они и летом потребляют пищу, а болезненные укусы ощущаются только ближе к началу осени. Причина в том. что с наступлением холодов популяция насекомых значительно увеличивается. Среди них обостряется конкуренция за источники питания. Находить еду становится труднее, поэтому насекомые приобретают агрессивность.
В это время они более злые, чем раньше, потому что голодны. Кроме того, в августе и сентябре мухи ищут подходящие места, где можно сделать кладку. Поэтому они подлетают ближе к человеческому жилью, проникают в квартиры и дома, ведь внутри благоприятная среда для развития молодых и зимовки взрослых особей.
Чтобы защитить себя от кусачих мух, достаточно принимать обычные меры профилактики. На окнах должны быть москитные сетки. Дома следует регулярно делать влажную уборку. Не нужно оставлять на столе пищу — лучше сразу убирать её в холодильник. Также необходимо соблюдать правила гигиены и использовать покупные препараты и приборы для борьбы с хищными двукрылыми насекомыми. Эффективные меры борьбы:
- спреи;
- ультразвуковые отпугиватели;
- ловчие ленты;
- инсектицидные лампы;
- фумигаторы.
Владельцам частных домов стоит заботиться о чистоте на прилегающей территории, не допускать скоплений мусора и бороться с растительностью.
Слепни и цеце
Агрессивная разновидность мух — слепни. Они кусаются и весной, и летом, но особенно агрессивными становятся незадолго до наступления осени. К этому времени они достигают 3 см в длину, и по этому признаку их легко отличить от комнатных мух. Чаще всего слепень имеет серый цвет, но встречаются и желтоватые, и бурые особи.
Больше всего этих насекомых вблизи водоёмов. В России они селятся у прудов, ручьёв, рек, поросших камышом. Сильно страдают от укусов слепней коровы, лошади и козы. Кровью питаются исключительно самки, а самцы довольствуются растительной пищей. Укус взрослого насекомого довольно болезненный. Симптомы, которые развиваются вскоре после атаки слепня:
- покраснение;
- опухоль;
- жжение;
- боль;
- зуд.

Нужно избегать мест, где много этих насекомых, так как они высасывают ощутимое количество крови. Известны случаи, когда люди, подвергшиеся атаке нескольких десятков насекомых, оказывались в реанимации. Для сравнения: за один укус слепень выпивает в 70 раз больше крови, чем комар. Опасность возникает ещё и из-за того, что прокол кожи сопровождается выбросом токсичного вещества, которое вызывает раздражение. Многое зависит от особенностей организма. Если человек в принципе невосприимчив к укусам насекомых, атака слепня обойдётся для него без выраженных последствий.

Муха-цеце — ещё один небезопасный вид кровососущих насекомых. Вероятность повстречать её в России крайне мала, но не исключена. Кроме того, нужно помнить об опасности, отправляясь на отдых в экзотическую страну. Это очень агрессивная разновидность насекомых. Они не только больно кусаются, но и представляют смертельную опасность, так как являются разносчиками сонной болезни.
Цеце — живородящая муха, то есть её потомство появляется на свет в виде жизнеспособной личинки, которая почти сразу превращается в полноценную особь. Возбудитель сонной болезни — трипаносом. Это паразитический одноклеточный организм, принадлежащий к семейству трипаносомадит. Попадая в организм человека, он провоцирует развитие заболевания. Иммунная система не может распознать чужеродный агент, так как трипаносом вырабатывает особые вещества. Поэтому после укуса цеце нужно срочно обратиться к врачу.
Оводы и мошки
На территории России оводы распространены повсеместно, за исключением Крайнего Севера. Есть несколько видов этих насекомых, причём одни нападают преимущественно на животных, другие — чаще всего на людей, однако опасность представляют многие разновидности.
Учёные установили, что взрослые особи не нуждаются в пище. Они кусают вовсе не для того, чтобы напиться крови. Овод протыкает кожу, чтобы сделать кладку. Личинка развивается в теле человека или животного, причём места могут быть такими:
- веки;
- спина;
- конечности;
- голова.

Опасности подвергаются открытые участки тела. Когда личинка развивается, она выгрызает плоть изнутри. Единственный метод лечения — удаление поражённого участка хирургическим путём.
Мошка — ещё одно кусачее насекомое, которое осенью становится особенно агрессивным. Этих кусачих двукрылых невозможно спутать с мухами, хотя они доставляют не меньше неприятностей. Мошки обычно летают роем. От укусов страдают такие участки тела:

- глаза;
- уши;
- рот;
- нос;
- голова;
- руки:
- ноги;
- спина.
Замечено, что мошки наиболее активны в вечернее и ночное время. Чаще они нападают на тех, у кого светлая одежда. Также есть сведения, что насекомых привлекает запах пота. Боль от укуса ощущается не сразу, так как при атаке насекомое впрыскивает в кровь вещество с обезболивающим эффектом, расширяющее сосуды.
Через несколько минут или часов появляются неприятные симптомы в виде зуда, жжения, покраснения. У людей, склонных к аллергии, появляется насморк, повышается температура, развивается отёчность. В такой ситуации нужно обратиться к врачу. Если симптомы не доставляют особого беспокойства, но всё же присутствуют, могут помочь народные средства. Эффективные меры для снятия отёка и зуда:
- лёд, завёрнутый в чистую ткань;
- листья мяты или мазь с ментолом;
- содовый компресс (1 ч. л. соды на 200 мл воды).
Состояние должно улучшиться через несколько минут. Чтобы в дальнейшем не подвергаться атакам мошки и других двукрылых кровососов, нужно надевать плотную одежду, закрывающую руки, ноги и шею. Полезно использовать репелленты, отпугивающие насекомых.





